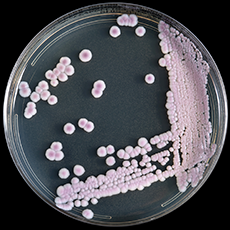

7年前這種新生物在三大洲同時出現造成感染和死亡,至今沒人能解釋它的起源_風聞
把科学带回家-把科学带回家官方账号-专注于孩子的科普教育2021-11-22 14:20
撰文 七君
7年前,三個大洲同時出現了一種新型感染,死亡率達到了30%-60%,造成感染的病原體並不存在於自然界。直到現在,還沒有人能夠解釋,為什麼它在三個大洲同時爆發。
2014年秋天,巴基斯坦阿迦汗大學附屬醫院發現了3個身患奇怪感染的病人。這些病人的感染症狀十分相似,但卻又是此前從未有過的。在接下來的半年裏,醫院裏出現了19個類似的感染病例,其中8人死亡。
因為這家巴基斯坦的醫院找不出病因,因此他們把樣本送到了美國疾病預防和控制中心(CDC)。美國疾病預防和控制中心發現,這種真菌是5年前發現的新物種——耳念珠菌(Candida auris),也叫耳道假絲酵母菌。
培養皿中的耳念珠菌呈現出粉色。圖片來源:CDC
念珠菌是一大類真菌,包含超過500個物種,它們大都居住在人體表面和腸道里。不過這種耳念珠菌卻是從人類耳朵裏冒出來的新菌。
2009年,日本東京都的一家老年醫院從一位70歲的老太的耳道里分離出了耳念珠菌。當時這種真菌並沒有引起重視,許多研究者甚至還不知道它的存在。
不過在“韜光養晦”5年後,耳念珠菌的流量值就飛速躥升,甚至獲得了“超級真菌”的“成就”。這是因為在被發現的短短5年後,耳念珠菌造成的感染突然在三個大洲同時爆發,而且直到現在人類還沒有搞明白這種同時性背後的原因。
實際上在巴基斯坦密集出現耳念珠菌感染病例的同時期,韓國、印度、委內瑞拉和南非也出現了耳念珠菌感染的爆發。英國最大的心肺醫療中心的皇家布朗普頓醫院(Royal Brompton Hospital)也出現了類似的感染。

圖片來源:pixabay
美國疾病預防和控制中心最初的想法是,亞美非三大洲的同時性可能來自國際旅行,比如攜帶着耳念珠菌的旅行者到處浪導致病菌擴散。該中心的傳染病學家 Snigdha Vallabhaneni 表示,美國疾病預防和控制中心的研究者還曾懷疑源頭是被污染的醫療用品,然而三個大洲的醫療用品同時被污染這件事很難想象。
但在比較了世界各地發現的耳念珠菌的基因序列後,上面的假設很快被推翻了。
實際上,全基因組重測序(WGS)顯示,這些耳念珠菌並不起源於同一處,它們並沒有同一個“爸爸”,而是各自獨立出現的;雖然三個大洲的耳念珠菌都屬於同一個物種,但它們可能早在數千年前就分化了,並在同一個時間點出現了致病性。

有人可能會説,耳念珠菌會不會早就在醫院裏潛伏了呢?
研究發現並沒有這回事。要知道在1997-2016年間,全世界40個國家的150個醫療中心參與了一個叫做 SENTRY 抗真菌監測計劃的真菌研究項目,這個計劃統計了這些醫院內發現的超過2萬份各種真菌樣本,但是在2009年以前,SENTRY 數據庫裏並沒有出現耳念珠菌的蹤跡。

關於耳念珠菌的起源目前有各式各樣的理論。排除了國際旅行和院內潛伏的可能性後,研究者們開始懷疑,這會不會是全世界的抗真菌藥物的鍋?
荷蘭研究者 Jacques Meis 認為,耳念珠菌的橫空出世和人類在農田中大量使用抗真菌劑——唑有關。不僅醫院會用三唑類抗真菌藥治療患者,農場也會給作物噴灑三唑類抗真菌製劑。這樣一波一波的人工選擇後,不會被殺死的傢伙能變得更強大。
美國疾病預防和控制中心的真菌學家 Tom Chiller 也有類似的觀點。他認為,具有感染性的耳念珠菌可能在環境中已經存在了很久了,當抗真菌劑殺死了占主導地位的其他真菌後,耳念珠菌就強勢出現,控制了空白的生態位。

一些研究者認為,由於抗真菌劑的廣泛使用,加之全球變暖等因素,耳念珠菌叢濕地等環境中傳播到人類的生活空間裏。圖片來源:The University of Texas MD Anderson Cancer Center
但這種假説所無法解釋的是,目前人類並沒有在自然環境或其他動物身上發現耳念珠菌,而其他種類的念珠菌卻廣泛存在於植物、昆蟲等自然環境裏。
總而言之,直到現在還沒人能解釋世界各地耳念珠菌感染突發的統一性。
除了神秘的起源,耳念珠菌還有其他“蜜汁”技能,比如耳念珠菌能忍受超咸和超高温的環境。
耳念珠菌可以在42攝氏度的環境下存活。實際上,很少有真菌能在37攝氏度的環境中存活,這也是為什麼發燒有用。其次,耳念珠菌可以在比海水還要鹹的滷水裏生存。

圖片來源:pixabay
也就是説,如果你煮了一鍋含鹽量為10%的40攝氏度的鹹湯,其他真菌都滷入味了,耳念珠菌還可以在裏面搓澡。
而根據 Chiller,耳念珠菌還具有其他已知真菌所不具備的超級技能,比如可以在人的體表,甚至物體表面長時間存活;另外,耳念珠菌能夠耐受醫院的消毒劑,比如季銨鹽。
最令醫療工作者頭疼的是,這樣強大的耳念珠菌還具有嚴重的抗藥性。
美國疾病預防和控制中心指出,90%的耳念珠菌感染對至少一種藥物具有耐藥性,而30%的耳念珠菌感染對至少2種藥物具有耐藥性。被耳念珠菌感染的患者中,約一半人會在90天內死去。
倫敦帝國理工學院的流行病學家 Johanna Rhodes 自2016年倫敦皇家布朗普頓醫院爆發耳念珠菌感染以來一直在研究這種微生物。她説,一般來説具有耐藥性的病原體會在其他方面付出代價,這被稱為適合度代價(fitness cost),就像武力值、智力值和運氣值拉滿的角色無法突破二次元一樣。但是耳念珠菌和大家似乎不在一條賽道上,“看起來它獲得了耐藥性,卻沒有付出適合度代價。”

圖片來源:pixabay
另外,耳念珠菌還可以形成乾燥的生物膜,覆蓋在醫院病房各處。這點也讓美國國家過敏和傳染病研究所所長安東尼·福奇(Anthony Fauci)感到迷惑不解:“為什麼其他真菌用什麼一擦就能抹掉,但是耳念珠菌卻還在那裏?”
因為不怕擦不怕殺,耳念珠菌成了很難甩掉的病房長期“伴侶”。西奈山醫院的院長 Scott Lorin 説:被耳念珠菌感染的患者呆過的地方“都是陽性,牆壁啊、牀啊、門啊、窗簾啊…”
因為具有上述強大的“魔法”屬性,2019年,美國疾病預防和控制中心把耳念珠菌列為“緊急威脅”(urgent threats)。
美國疾病預防和控制中心表示,耳念珠菌雖然是在2009年出現的,但是正在許多國家快速傳播。根據該中心在2021年2月15日收集和公佈的數據,全球至少有49個國家發現了耳念珠菌感染病例,感染地圖覆蓋了東亞、南亞、南美、南非。
2019年,我國也出現了耳念珠菌感染病例,“中國18例超級真菌”的新聞還一度登上了百度搜索熱點。

Chiller 感嘆道:“耳念珠菌是從黑暗中突然冒出來的,但現在到處都是。” Vallabhaneni 也對耳念珠菌不同尋常的演化曲線表示不解:“耳念珠菌突然同時在各處出現,又具有耐藥性,這真的太驚人了。”
所幸的是,耳念珠菌目前只對免疫力低下的人羣有威脅,健康人沒必要過分擔憂。2019年,中國疾控中心傳染病預防控制所助理研究員龔傑這樣安慰大家:“超級真菌不感染健康人”。
好不容易出現了受得了熱辣鹹濕的人類的生物,反而不受人類待見。
封面來源:pixabay
參考資料:
https://docs.qq.com/doc/DVG1tS2FlVnNja1lN